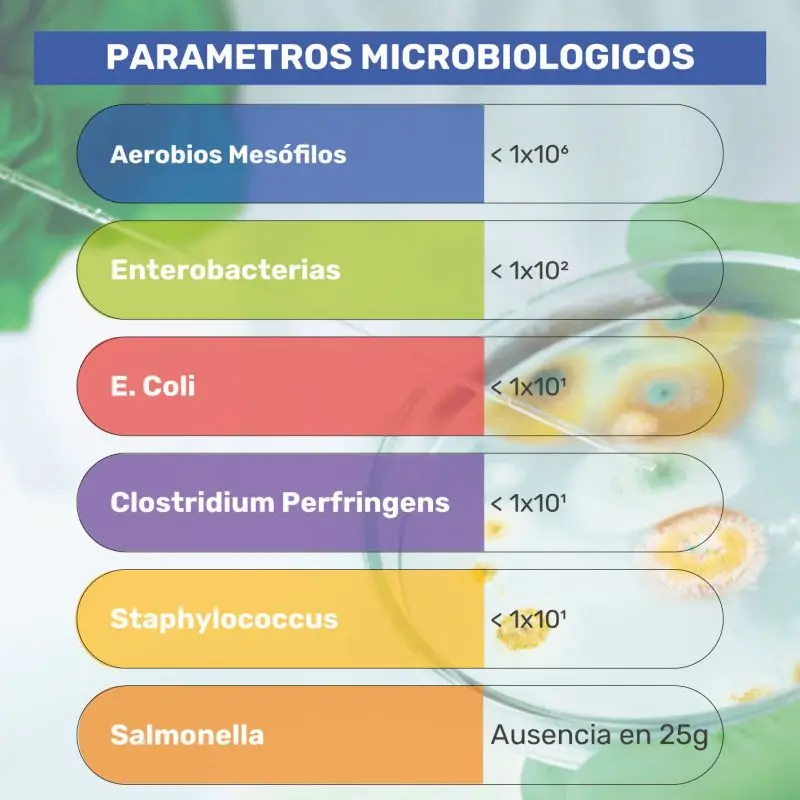

Contra con Picaña Hembra Black Premium







Producido por TIERNATUR CARNE DE ORIGEN S.L. B-54940945 | R.G.S.E.A.A.: 10.026242/A | Reg.Halal: IH-1141/1.2/A/18 | Ctra Madrid Km4 Módulos 200.200B - 201.203 | +34 966 937 505
FICHA TÉCNICA

Imágenes de carácter ilustrativo. Los productos pueden variar
Código del Producto
xxxx
Nombre del Producto
Contra con Picaña de Hembra Black Premium
Contra de Vacuno. Pieza perteneciente a la bola, deshuesada y perfilada.
Tipo de Envasado
AL VACIO
Conservación
0° Y 3°
en Fresco
30 Días
de Caducidad
Carne
100% de Añoja
7-8Kg
Aproximadamente
Pastoreo Extensivo
Cereales
Buena Infiltración
Sabor caracteristico

ENVASE
UNIDADES POR ENVASE: 1
PESO APROXIMADO: 7-8Kg
FORMATO: AL VACIO
FORMATO DE CAJA
M1 (598x393x185)
3
Unidades por Caja
20-24Kg
Peso por Caja
PALET
MEDIDAS: 800mm x 1200mm
32
Cajas por Palet
640-768Kg
Peso por Palet

PARAMETROS MICROBIOLOGICOS
|
Aerobios Mesófilos |
< 1x106 |
|
Enterobacterias |
< 1x102 |
|
E. Coli |
< 1x101 |
|
Clostridium Perfringens |
< 1x101 |
|
Staphylococcus |
< 1x101 |
|
Salmonella |
Ausencia en 25g |

PARAMETROS MICROBIOLOGICOS
|
Aerobios Mesófilos |
< 1x106 |
|
Enterobacterias |
< 1x102 |
|
E. Coli |
< 1x101 |
|
Clostridium Perfringens |
< 1x101 |
|
Staphylococcus |
< 1x101 |
|
Salmonella |
Ausencia en 25g |

|
Aerobios Mesófilos |
< 1x106 |
|
Enterobacterias |
< 1x102 |
|
E. Coli |
< 1x101 |
|
Clostridium Perfringens |
< 1x101 |
|
Staphylococcus |
< 1x101 |
|
Salmonella |
Ausencia en 25g |
PARAMETROS MICROBIOLOGICOS

RECOMENDACIÓN DE COCINADO
Realizar tratamiento térmico antes de su consumo.
DECLARACIÓN DE ALÉRGENOS:
No hay restricción en ningún ámbito de población.
